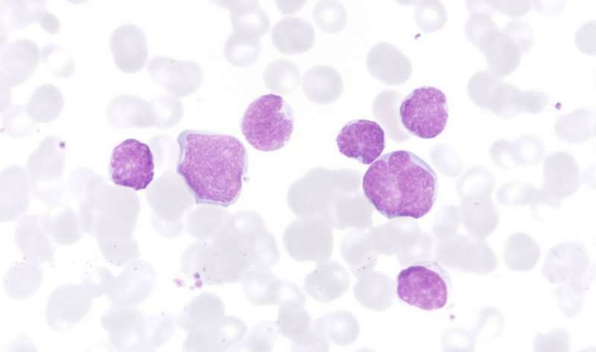

新闻资讯
本专题为癌症123的癌症专题,内容全部来自癌症123精心选择与癌症相关的最近资讯,癌症123读懂智能与未来,拥有癌症资讯的信息,在这里你能看到未来的世界。
*以上解读内容仅供参考,癌症123不对解读内容负责。
"合成致死" 创新癌症公司 A 轮获 5500 万美元
2017-04-01国际知名投资机构 Third Rock Ventures 宣布推出一家名为 Tango Therapeutics 的癌症新型疗法公司,旨在针对突变致癌基...
专访DNA之父詹姆斯·沃森:人类离治愈癌症还有多远?
2017-04-013 月 29 日,DNA 之父、美国生物学家、诺贝尔奖生理学或医学奖获得者詹姆斯·沃森接受了新华社专访,并就治愈癌症等一系列话题展开对话。 人类离治愈癌...
癌细胞会隐身,传播癌症“肆无忌惮”
2017-04-01科学家已经发现侵略性子宫癌中的肿瘤细胞如何切换伪装并如此迅速地传播到身体其他部位。在 Neoplasia 发表的一项研究中,华盛顿大学医学院的研究人员...
垃圾 DNA 是诱发癌症的动力
2017-04-01根据“人类卫星二”,人类基因组认为是“垃圾 DNA”的异常高拷贝但未被探索的序列具有令人惊讶的能力,影响我们基因组的主要监管者。放松管制时,这些重复...
高剂量的维生素 C 可改善癌症治疗已通过人体安全性试验
2017-04-01临床试验发现,定期为脑和肺癌患者注入 800-1000 倍的日常推荐量的维生素 C 作为改进标准癌症治疗结果的潜在策略是安全的。在 2011 年 3 月 30 日提交...
让癌细胞在黑暗中“发光”,将其一举抓获
2017-03-31如果我们可以在癌细胞表面“粘黏”荧光物质,会怎么样呢?外科医生对于哪里有癌细胞一目了然。这就是密歇根科技大学研究人们的一次新的研究:荧光探针。研...
重离子治癌进入临床准备
2017-03-31高大上的物理科研仪器,也可以用来治疗癌症。目前,我国已启动重离子治癌项目,用碳离子“精准射击”破坏癌细胞。昨天,中国科学院通报“十三五”促进经济社会发展重大科...
减重或降低老年女性患子宫内膜癌的风险
2017-03-31美国一项新的研究显示,体重减轻也许能够降低老年女性患子宫内膜癌的风险。 相关研究人员表示,很多老年人认为,到老的时候减重没有任何意义。因为肥胖对身体的...
高强度聚焦,集中“烧死”癌细胞
2017-03-31高强度聚焦超声 (HIFU) 是一种治疗肿瘤的突破性技术。这种非侵入性靶向治疗的原则, 就好像通过透镜聚焦的阳光一样,使用一个像凸透镜的超声换能器将超...
白血病:表观遗传病变是患病的“罪魁祸首”
2017-03-31来自 Bellvitge 生物医学研究所(IDIBELL)的 Manel Esteller 博士领导的表观遗传学和癌症生物学计划(PEBC)的研究人员已经发现表观遗传损伤如何导致 T 细胞...
简单修改迫使癌细胞“集体自杀”
2017-03-29目前,化疗仍然是治疗癌症的最佳选择,然而,其副作用却令人唏嘘。很多癌症患者都在与化疗的副作用斗争着。而且对于胰腺癌和其他一些侵略性癌症而言,情况更加严峻,那就是根本就没有有效的治疗...
肿瘤如何利用代谢途径繁荣昌盛?
2017-03-29代谢异常是肿瘤的主要特征之一。近年来不少研究表明肿瘤或机体代谢产物或者代谢通路在肿瘤发生发展中发挥重要作用。在此,小编盘点了近期关于肿瘤代谢的最新研究进展。与大家分...
表观遗传如何让癌症在歧途越走越远?
2017-03-29表观遗传学是近年来新兴的一个学科,目前研究处于快速发展阶段。越来越多的证据表明表观遗传在人体生长、发育、疾病过程中发挥着重要作用,不少研究也表明表观遗传的改变是癌症发...
Nat Commun:华人科学家借助PDX模型寻找乳腺癌个体化治疗新策略
2017-03-29癌症治疗的目的在于摧毁肿瘤,阻止肿瘤生长和扩散。为达到该目标,来自贝勒医学院和华盛顿大学医学院等研究机构的研究人员开发了一种寻找乳腺癌治疗策略的新方法。他们首先鉴定一...
FDA批准第三个PARPi卵巢癌新药niraparib
2017-03-29今日,药明康德合作伙伴TESARO迎来重磅喜讯——其PARP抑制剂niraparib (商品名ZEJULA)获得了美国FDA的批准上市,用于复发性上皮卵巢癌、输卵管癌或原发性腹膜癌女性患者的维持治疗。这些患...
Nature:斯坦福发现新抗原靶点,个体化治疗淋巴瘤
2017-03-29癌症体细胞在突变后可以产生用于区分恶性细胞与正常细胞的新抗原(neoantigens)。然而,在肿瘤研究领域,如何在个体化层面鉴定这类新抗原和相关验证仍然是一巨大挑战。...
尖端精密的肿瘤治疗技术——粒子植入技术
2017-03-29中国的癌症发病率和死亡率一直在上升,从2010年开始已经成为主要的致死原因,成为了中国的一个主要公共卫生问题。根据统计数据报告,仅在2015年,我国共有429.2万新发肿瘤病例和281.4万癌症死...
盘点:肿瘤领域近期进展汇总
2017-03-291.无创检测:大数据分析!一滴血便可检测是否患癌
美国知名研究学者近期开发出一款软件,能帮助临床人员对患者的血液进行分析,快速判断患者是否患有癌症,并且能定位癌变的位点。这项研究于本...
美国知名研究学者近期开发出一款软件,能帮助临床人员对患者的血液进行分析,快速判断患者是否患有癌症,并且能定位癌变的位点。这项研究于本...
癌症早期诊断液体活检市场井喷!引发大量投资!
2017-03-29开发基于血液检测的癌症早期筛查方法已经吸引了高度的注意,这并不是什么新闻,因为过去几年已经吸引了大量关注和投资。正在发生改变的是投资人员对筛查和早期诊断(而不仅仅是监...
大型研究发现与脑癌相关的基因变异
2017-03-29在美国有成千上万的人患脑部肿瘤。神经胶质瘤是一类特殊的恶性脑肿瘤,包括胶质母细胞瘤——一种低生存率的肿瘤。最新研究揭示了与神经胶质瘤风险增加...
Science:多数癌症基因突变要怪 “坏运气”
2017-03-29自约翰·霍普金斯大学的科学家曾在 两年前发表论文 说,多数癌症发病要怪 “坏运气”,遗传和环境因素影响相对较小。这一结论在科学界引起巨大争议。...
警惕:皮肤上出现这样的疙瘩可能是癌症信号
2017-03-29皮肤上会出现各种不同的疙瘩,虽然大多数都不会有什么严重的并发症,但是也有一些是癌症的信号。 在本文中, 我们来看一下皮肤上常见的疙瘩症状, 诊断和...
口服避孕药不仅不会致癌,还能够防癌
2017-03-29在谈到口服避孕药时,女性经常会听到避孕药会使得她们罹患癌症的风险增加。然而,一项最新研究发现,使用避孕药预防某些癌症的时间至少长达 30 年之久。 ...
国家癌症中心:每7分钟就查出1人患癌,这些信号要注意!
2017-03-29近日,国家癌症中心发布了2017中国城市癌症数据最新报告,汇总了全国347家癌症登记点的数据: ▼我国每天约有1万人确诊癌症,相当于平均每7分钟就有一个人得癌症。 ▼到85岁,一个人...